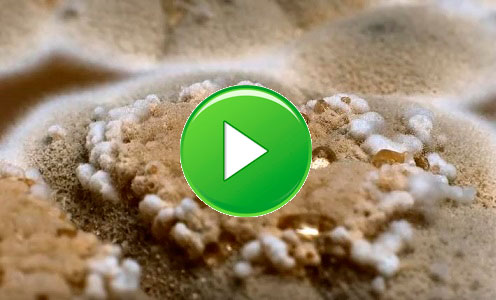

Аэробные микроорганизмы, хорошо растут на различных субстратах.
Аэробные микроорганизмы, хорошо растут на различных субстратах.
Образуют плоские пушистые колонии, вначале белого цвета, а затем, в зависимости от вида, они принимают разную окраску, связанную с метаболитами гриба и спороношением.
Мицелий гриба очень сильный, с характерными для высших грибов перегородками.
Аспергиллы распространяются спорами, образующимися бесполым путем, что характерно для всего класса вообще.
В то же время Aspergillus fumigatus может размножаться половым путём.
Рост и распространение
Аспергиллы относят к грибам дейтеромицетам, не имеющим половой стадии развития. С появлением данных анализа ДНК стало более вероятно, что все члены рода аспергилл близкородственны аскомицетам, и их следует считать представителями аскомицетов.
Представители рода обладают способностью расти везде, где присутствует высокая осмотическая концентрация (крепкие растворы сахара, соли и т. д.), и очень устойчивы к воздействиям внешней среды.
Аспергиллы — высокоаэробные виды, и их можно обнаружить почти во всех богатых кислородом средах, где они обычно растут как плесень на поверхности субстрата, как следствие высокого обогащения кислородом.
Как правило, грибы растут на богатых углеродом субстратах, таких как моносахариды (к примеру, глюкоза) и полисахариды (например, амилоза). Виды аспергилл являются распространённым заражающим фактором крахмалистых продуктов (таких, как хлеб и картофель) и растут внутри либо на поверхности многих растений и деревьев.
СЗМ-скан спор аспергилла, выращенного на чайной культуре на стеклянной подложке
Помимо роста на источниках углерода, многие виды рода аспергилл демонстрируют олиготрофность, то есть способность к росту в обеднённых питательными веществами средах, либо в условиях совершенного отсутствия ключевых питательных веществ. Главным примером этого является A. niger - его можно обнаружить растущим на влажных стенах как основной компонент ложной мучнистой росы - милдью (англ.).
Значение для человека
Виды аспергилл важны с медицинской и коммерческой точки зрения. Отдельные виды могут инфицировать человека и других животных. Некоторые инфекции, найденные на животных, изучались годами; в то время как другие виды, найденные на животных, описывались как новые и специфические для исследуемого заболевания. Иные были известны как уже использующиеся названия для организмов, таких как сапрофиты.
Более 60 видов аспергилл являются существенными медицинскими патогенами. Существует целый ряд заболеваний человека, таких, как инфекция наружного уха, поражения кожи и изъязвления, классифицируемые как мицетомы.
Другие виды важны в промышленности при изготовлении ферментативных препаратов. К примеру, спиртные напитки, такие как японская саке, предпочитают делать из риса или других крахмалистых ингредиентов (таких как маниока), вместо винограда или солодового ячменя. Типичные микроорганизмы, использующиеся для производства спирта, такие, как дрожжевые грибки рода сахаромицеты, не могут ферментировать крахмал.
Поэтому для расщепления крахмала на более простые сахара используется плесень кодзи (например, Aspergillus oryzae). Aspergillus oryzae, Aspergillus sojae, Aspergillus tamari используются для приготовления соевого соуса, а также различных видов соевой пасты - мисо, твенджана и других.
Грибы Aspergillus находят широкое применение для определения содержания неорганических катионов и анионов. Представители рода Аспергиллы также являются источниками натуральных веществ, которые могут быть использованы в производстве медикаментов для лечения различных заболеваний человека. Возможно, самое обширное применение имеет Aspergillus niger, как основной источник лимонной кислоты.
Этот организм обеспечивает 99 % объёма мирового производства лимонной кислоты - это более 1,4 миллиона тонн в год. A. niger также часто используется для получения истинных (нативных) и инородных ферментов, включая глюкозооксидазу и лизоцим белка куриных яиц. В таких случаях культуру редко выращивают на твёрдом субстрате (хотя в Японии эта практика ещё распространена). Чаще её выращивают как глубинную культуру в биореакторе.
При таком способе можно жёстко контролировать важные параметры и достичь максимальной продуктивности. Этот процесс также сильно облегчает отделение целевого химиката или фермента от питательной среды и, следовательно, намного более рентабелен.
ASPERGILLUS
Исследования
Четыре колонии Аспергилл трёхдневной выдержки: По часовой стрелке с левого верхнего: лабораторный штамм A. nidulans; аналогичный штамм с мутацией в сигнальном гене yA, отвечающем за зелёную пигментацию; штамм A. oryzae, использующийся при ферментации сои; A. oryzae RIB40 Микрофотография Аспергилла, сделанная РЭМ при увеличении в 235 крат.
A. nidulans долгие годы использовался в качестве подопытного организма. Итальянский генетик и микробиолог Гвидо Понтекорво использовал гриб для демонстрации парасексуального процесса у грибов. A. nidulans стал в недавнем времени одним из первых организмов, чей геном был секвенирован исследователями Института Илай и Эдиты Л. Брэд (англ.). Начиная с 2008 года, был секвенирован геном ещё семи представителей рода Аспергиллы: использующиеся в промышленности A. niger (два штамма), A. oryzae (англ.) и A. terreus (англ.), A. fischerianus (Neosartorya fischeri), A. flavus и A. fumigatus (два штамма). A. fischerianus почти никогда не бывает патогенным, однако имеет близкое родство с часто встречающимся патогеном A. fumigatus; он был частично секвенирован с целью лучшего понимания механизмов патогенности A. fumigatus.
Плесень
Половая репродукция
Из 250 видов аспергилл около 64 % не имеют известной половой стадии.[10] Тем не менее, становится всё более ясно, что многие из этих видов, вероятно, имеют пока что неидентифицированную половую стадию. Половое размножение у грибков происходит двумя фундаментально различающимися способами.
Это ауткроссинг (перекрёстное скрещивание) у гетероталломных (англ.) грибков, в процессе которого две разные особи обмениваются ядрами, и самооплодотворение у гомоталломных (англ.) грибков, где оба ядра происходят от одной и той же особи.
В последние годы половые циклы были обнаружены у большого числа видов, ранее считавшихся бесполыми. Эти открытия отражают сосредоточенность современных эмпирических исследований на видах, имеющих конкретное отношение к человеку. Некоторые виды, для которых недавно подтверждено половое размножение, описаны ниже.
A. fumigatus - вид аспергилл, наиболее часто вызывающий иммунодефицит человека. В 2009 году было выявлено, что A. fumigatus имеет полнофункциональный гетероталломный половой цикл. Для начала процесса размножения требуются изоляты штаммов с комплементарными типами спаривания.
Четыре колонии Аспергилл трёхдневной выдержки: По часовой стрелке с левого верхнего: лабораторный штамм A. nidulans; аналогичный штамм с мутацией в сигнальном гене yA, отвечающем за зелёную пигментацию; штамм A. oryzae, использующийся при ферментации сои; A. oryzae RIB40
A. flavus - основной продуцент канцерогенного афлатоксина у зерновых культур по всему миру. Это также оппортунистический человеческий и животный патоген, вызывающий аспергиллёз у особей с ослабленным иммунитетом. В 2009 году у этого гетероталломного грибка была обнаружена половая стадия, возникающая при совместном развитии штаммов с противоположными половыми типами в подходящих условиях.
A. lentulus - оппортунистический патоген человека, который вызывает инвазивный аспергиллёз с высоким уровнем смертности. Гетероталломная функциональная система размножения у A. lentulus была обнаружена в 2013 году.
A. terreus широко используется в промышленности для производства важных органических кислот и ферментов, а также ранее служил основным источником для производства понижающего уровень холестерина препарата Ловастатин. В 2013 году было обнаружено, что A. terreus способен к половому воспроизведению, когда штаммы с противоположными половыми типами скрещивались в подходящих для культуры условиях.
Эти результаты исследований видов Аспергилл согласуются с данными, накопленными при изучении других видов эукариот, и свидетельствуют о вероятном наличии полового поведения у общего предка всех эукариот.A. nidulans - гомоталломный грибок, способный к самооплодотворению.
Самооплодотворение затрагивает активацию тех же путей полового размножения, что и у видов, скрещивающихся ауткроссингом. Имеется в виду не то, что самооплодотворение проходит необходимые стадии, характерные для ауткроссинга, а то, что вместо этого требуется активация этих механизмов в пределах единственного представителя вида. Подавляющее большинство видов Аспергилл, демонстрирующих половые циклы, по природе гомоталломно (самооплодотворяющиеся).
Такое наблюдение предполагает, что в целом виды Аспергилл могут поддерживать половое размножение, даже несмотря на низкий уровень генетического разнообразия потомства как следствие гомоталломного самооплодотворения. A. fumigatus - гомоталломный (размножающийся ауткроссингом) грибок, который встречается в зонах, значительно различающихся климатом и условиями среды.
Этот вид также демонстрирует низкую степень изменчивости и в пределах географических регионов, и в масштабах планеты, вновь наводя на мысль, что половое размножение - в данном случае размножение ауткроссингом - может сохраняться даже при низкой степени генетической изменчивости.
Геномика
Одновременная публикация трёх рукописей на тему генома Аспергилл в журнале «Nature» в декабре 2005 года сделала этот род ведущим объектом для исследований по сравнительной геномике среди мицеллярных (нитевидных) грибков. Как и большинство геномных проектов, эти усилия предпринимались крупными центрами по секвенированию совместно с соответствующими научными сообществами.
К примеру, Институт изучения генома (TIGR) (англ.) работал с сообществом по изучению A. fumigatus. A. nidulans был секвенирован в Институте Илай и Эдиты Л. Брэд (англ.) A. oryzae был секвенирован в Японии в Национальном институте передовой промышленности и технологий.
Объединённый институт генома (англ.) Министерства Энергетики опубликовал секвенированные данные по геному штамма A. niger, использующегося для производства лимонной кислоты. TIGR, теперь переименованный в Институт Вентера (англ.), в настоящее время возглавляет проект генома вида A. flavus.
Размеры секвенированных геномов видов Аспергилл колеблются в пределах 29,3 Мб у A. fumigatus и 37,1 Мб у A. oryzae, в то время как количество предсказанных генов варьируется от ~9926 у A. fumigatus до ~12,071 у A. oryzae. Размер генома у ферменто-продуцирующего штамма A. niger среднего размера и составляет 33,9 Мб.
Патогены
Некоторые виды аспергилл вызывают серьёзные заболевания у людей и животных. Наиболее часто патогенность проявляют виды A. fumigatus и A. flavus, производящие афлатоксин, который одновременно является и токсином, и канцерогеном.
Он может заражать пищу, например, орехи, семена и зерно. Распространёнными возбудителями различных аллергических заболеваний являются виды A. fumigatus и Aspergillus clavatus (англ.). Другие виды важны как патогены сельскохозяйственных культур. Представители вида Аспергиллы вызывают заболевания у многих зерновых, особенно у кукурузы; некоторые синтезируют микотоксины, включая афлатоксин.
Аспергиллёз
Аспергиллёз - группа заболеваний, вызываемых грибами рода Аспергиллы. Наиболее распространённый подтип инфекций придаточных пазух носа, ассоциируемый с аспергиллёзом, вызывается видом A. fumigatus.
Симптомы включают жар, кашель, боль в груди или диспноэ (одышку), что также проявляется и в случае многих других заболеваний и поэтому может усложнить диагностику. Обычно восприимчивы только пациенты с уже ослабленной иммунной системой или страдающие от других болезненных лёгочных состояний.
Аспергиллёз лёгких
Главными формами заболевания у человека являются:
Аллергический бронхолёгочный аспергиллёз, поражающий больных с респираторными инфекциями, такими, как астма, муковисцидоз (кистозный фиброз), и синусит
Острый инвазивный аспергиллёз - форма аспергиллёза, при которой грибки прорастают в окружающие ткани, более часто случается у людей с ослабленной иммунной системой, например на фоне СПИДа или обусловленной курсом химиотерапии
Рассеянный инвазивный аспергиллёз - инфекция, широко распространившаяся в организме
Аспергилома (англ.) - шаровидное грибковое образование, которое может сформироваться в пазухах и полостях, например, в лёгких.
Чаще всего грибок проникает внутрь через дыхательные пути и рот и может поражать как дыхательную систему, так и центральную нервную систему, пищеварительный тракт, кожу, органы чувств и половую систему. Аспергиллёзный менингит или энцефалит в большинстве случаев заканчивается летальным исходом.
Встречаются также грибковые поражения селезенки, почек и костей аспергиллами, однако большей частью они вызваны вторичной инфекцией. Аспергиллёз дыхательных путей часто диагностируют у птиц и известны определённые виды аспергилл, заражающие насекомых.
Применение
Некоторые виды грибов этого рода используются человеком:
штаммы Aspergillus niger широко применяются для биосинтеза лимонной кислоты
Aspergillus oryzae, Aspergillus sojae, Aspergillus tamari используются для приготовления соевого соуса, а также различных видов соевой пасты — мисо, твенджана и других.
Грибы Aspergillus находят широкое применение для определения содержания неорганических катионов и анионов.
Грибы рода Aspergillus как инфицирующий фактор
В редких случаях некоторые грибы рода Aspergillus могут быть причиной заболевания, называемого аспергиллёзом. Аспергиллёз характерен в основном для лиц с различными иммунодефицитами.
Грибок проникает внутрь через дыхательные пути и рот и может поражать дыхательную систему, центральную нервную систему, пищеварительный тракт, кожу, органы чувств и половую систему.
В случае поражения дыхательной системы может иметь место легочный аспергиллёз. Аспергиллёзный менингит или энцефалит в большинстве случаев заканчивается летальным исходом. Встречаются также грибковые поражения селезенки, почек и костей аспергиллами, однако большей частью они вызваны вторичной инфекцией.